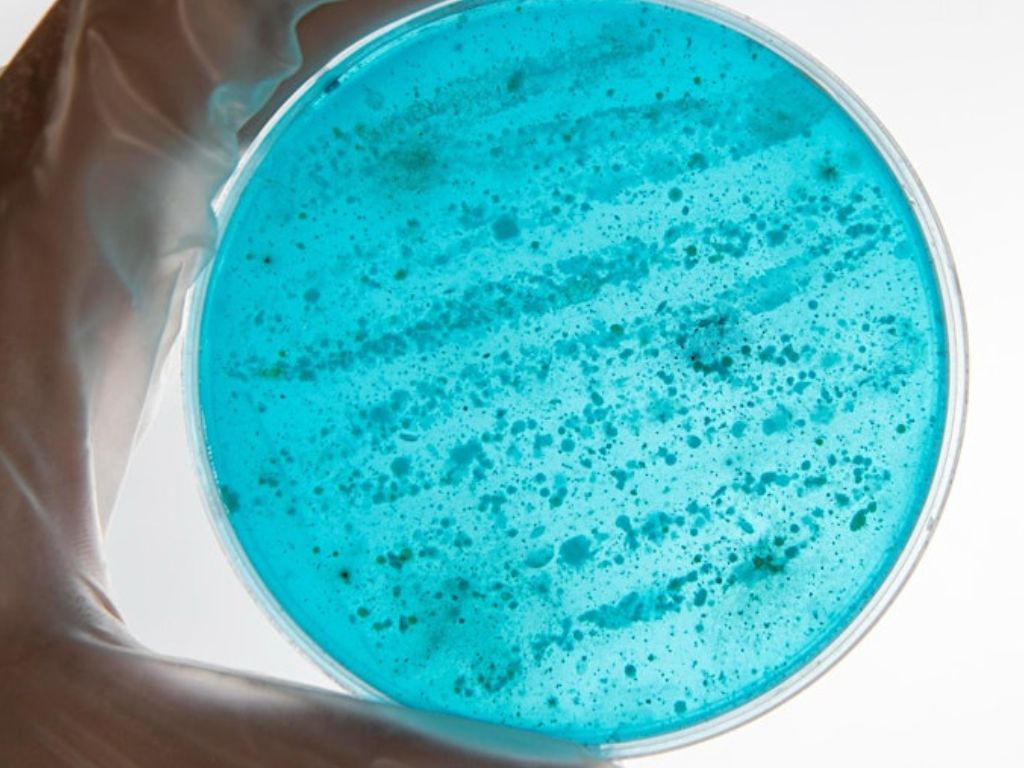

Nature’s Hardware Store: Building the Future with Biology 2025EXPIRED
published: 05 Oct 2025, 3 min read, 'EVENT EXPIRED'
when: 14 Oct 2025 | cost: $28.52 to $108.55 | address: Gateway Pavilion - Pier 2, Fort Mason Center, Marina Boulevard, San Francisco, CA 94123, United StatesThe Long Now Foundation welcomes
Lynn Rothschild
Nature’s Hardware Store: Building the Future with Biology
Attend the Long Now Talks in-person or via our livestream
Mix & mingle over drinks & small bites with other attendees at our pre & post-show gathering in the re-imagined Cowell Theater Lobby!
What if the solutions to humanity’s greatest challenges — on Earth and beyond — have already been invented by nature? In this forward-looking talk, evolutionary biologist and astrobiologist Dr. Lynn Rothschild explores how life’s patterns, materials, and mechanisms, refined over billions of years, can serve as a blueprint for building better futures on Earth and other planets.
Drawing on insights from deep time, Dr. Rothschild will open the doors to “Nature’s hardware store” — a vast, largely untapped reservoir of biological strategies available to scientists, engineers, and innovators. From self-healing materials and bio-inspired architecture to regenerative systems for space exploration, she reveals how biology is shaping the frontiers of technology and inspiring bold, surprisingly practical solutions to complex problems.
Grounded in astrobiology and evolutionary insight, this talk invites us to rethink innovation through the lens of life itself and to explore what’s possible when we tap into nature’s storehouse of intelligence to solve the challenges of tomorrow.
Event Details
Are we missing something? Help us improve this event. Reach out to us.
Are you looking for other similar events/articles?
Check out events/articles with the category: Things To DoFind events near: San Francisco
Other recent events
Shopping Cart
Your cart is empty.